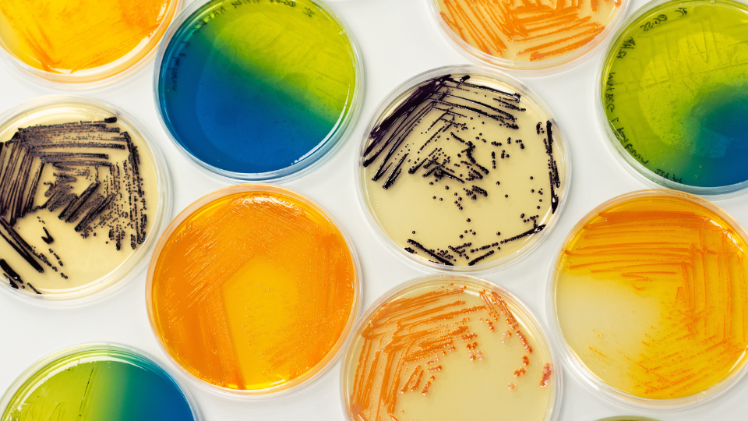

Events

Date: 15/04/2026
Time: 1:00PM - 2:00PM
Location: Lecture Theatre (LG.012), School of Biological Sciences
Category: Lecture / Talk / Discussion

Date: 22/04/2026
Time: 1:00PM - 2:00PM
Location: Lecture Theatre (LG.012), School of Biological Sciences
Category: Lecture / Talk / Discussion

Date: 8/05/2026
Time: 9:30AM - 3:00PM
Location: The School of Biological Sciences, 19 Chlorine Gardens, Belfast BT9 5DL
Category: Information Event

Date: 1/04/2026
Time: 11:00AM - 12:00PM
Location: Online
Category: Information Event

Date: 26/03/2026
Time: 1:00PM - 2:00PM
Location: Online
Category: Lecture / Talk / Discussion

Date: 25/03/2026
Time: 1:00PM - 2:00PM
Location: Lecture Theatre (LG.012), School of Biological Sciences
Category: Lecture / Talk / Discussion
-750x421.png)
Dates: 18/03/2026 - 19/03/2026
Time: 10:00AM - 5:00PM
Location: Isdell Courtyard, Riddel Hall
Category: Workshop / Seminar / Course

Date: 18/03/2026
Time: 1:00PM - 2:00PM
Location: Lecture Theatre (LG.012), School of Biological Sciences
Category: Lecture / Talk / Discussion

Date: 10/03/2026
Time: 10:00AM - 2:00PM
Location: QUB School of Biological Sciences, Main Foyer, 19 Chlorine Gardens, BT9 5DL
Category: Fair

Date: 4/03/2026
Time: 1:00PM - 2:00PM
Location: Lecture Theatre (LG.012), School of Biological Sciences
Category: Lecture / Talk / Discussion
-750x421.png)
Date: 26/02/2026
Time: 5:00PM - 7:31PM
Location: Isdell Courtyard, Riddel Hall
Category: Lecture / Talk / Discussion

Date: 25/02/2026
Time: 1:00PM - 2:00PM
Location: Lecture Theatre (LG.012), School of Biological Sciences
Category: Lecture / Talk / Discussion

Date: 21/02/2026
Time: 11:00AM - 12:00PM
Location: Ulster Museum, Belfast BT9 5AB
Category: General / Other, Lecture / Talk / Discussion

Date: 18/02/2026
Time: 1:00PM - 2:00PM
Location: Lecture Theatre (LG.012), School of Biological Sciences
Category: Lecture / Talk / Discussion

Date: 17/02/2026
Time: 7:00PM - 8:00PM
Location: School of Biological Sciences, 19 Chlorine Gardens, Belfast BT9 5DL
Category: Lecture / Talk / Discussion

Date: 17/02/2026
Time: 5:30PM - 9:00PM
Location: Whitla Hall, Queen's University, Belfast
Category: Information Event
Date: 14/02/2026
Time: 10:30AM - 1:30PM
Location: School of Biological Sciences, 19 Chlorine Gardens, Belfast BT9 5DL
Category: Exhibition, General / Other

Date: 11/02/2026
Time: 7:00PM - 8:00PM
Location: School of Biological Sciences, 19 Chlorine Gardens, Belfast BT9 5DL
Category: Lecture / Talk / Discussion

Date: 21/01/2026
Time: 12:00PM - 2:00PM
Location: Foyer, School of Biological Sciences
Category: Fair

Date: 20/01/2026
Time: 12:00PM - 2:00PM
Location: Foyer, School of Biological Sciences
Category: Fair

Date: 10/12/2025
Time: 1:00PM - 2:00PM
Location: Lecture Theatre, School of Biological Sciences
Category: Workshop / Seminar / Course

Date: 2/12/2025
Time: 1:00PM - 2:00PM
Location: Lecture Theatre, School of Biological Sciences
Category: Workshop / Seminar / Course

Date: 26/11/2025
Time: 1:00PM - 2:00PM
Location: Lecture Theatre, School of Biological Sciences
Category: Workshop / Seminar / Course

Date: 19/11/2025
Time: 12:00PM - 1:00PM
Location: Online
Category: Workshop / Seminar / Course

Date: 15/10/2025
Time: 2:30PM - 4:00PM
Location: Riddel Hall, 185 Stranmillis Rd, Belfast BT9 5EE
Category: General / Other, Lecture / Talk / Discussion

Date: 15/10/2025
Time: 1:00PM - 2:00PM
Location: Lecture Theatre, School of Biological Sciences
Category: Workshop / Seminar / Course

Date: 14/10/2025
Time: 10:00PM - 12:00PM
Location: Boardroom, School of Biological Sciences
Category: Workshop / Seminar / Course

Date: 8/10/2025
Time: 2:00PM - 3:00PM
Location: Lower Atrium, School of Biological Sciences, 19 Chlorine Gardens, Belfast BT9 5DL
Category: General / Other

Date: 1/10/2025
Time: 2:00PM - 3:00PM
Location: Lower Atrium, School of Biological Sciences, 19 Chlorine Gardens, Belfast BT9 5DL
Category: General / Other, Lecture / Talk / Discussion

Date: 11/09/2025
Time: 10:00AM - 4:30PM
Location: School of Biological Sciences, 19 Chlorine Gardens, Belfast, BT9 5DL
Category: Information Event

Date: 3/09/2025
Time: 1:00PM - 2:00PM
Location: Seminar Room, Patrick G Johnston Centre for Cancer Research
Category: Workshop / Seminar / Course

Date: 30/07/2025
Time: 1:00PM - 2:00PM
Location: Seminar Room 1 (LG.023), School of Biological Sciences
Category: Workshop / Seminar / Course

Date: 12/06/2025
Time: 12:00PM - 1:00PM
Location: Seminar Room 1 (LG.023), School of Biological Sciences
Category: Workshop / Seminar / Course
-750x446.png)
Date: 26/05/2025
Time: 6:30PM - 7:30PM
Location: Great Hall, Queen's University Belfast
Category: Lecture / Talk / Discussion
 cropped-750x410.png)
Date: 22/05/2025
Time: 9:30AM - 12:00PM
Location: School of Biological Sciences Lecture Theatre, Lower Ground Floor
Category: Lecture / Talk / Discussion
 (1)-750x450.png)
Date: 19/05/2025
Time: 12:30PM - 2:00PM
Location: Biological Sciences Lecture Theatre, Lower Ground Floor
Category: Lecture / Talk / Discussion
